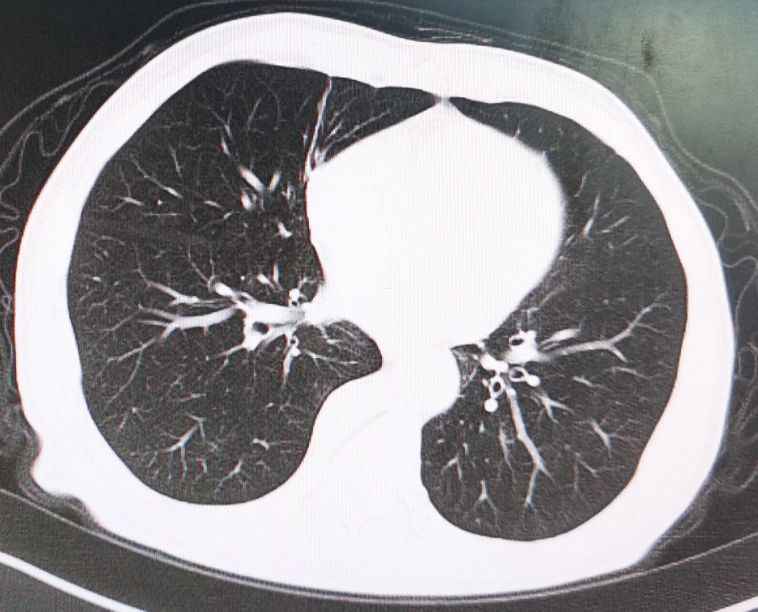
直肠癌转移肺部ct报告单怎样提示,直肠癌转移到肝肺部还能活多久

这个病人是降结肠癌伴梗阻做的腹腔镜下降结肠癌根治术。术后病理报告:中低分化腺癌,已经侵透肠壁,淋巴结转移(6/13),并可见脉管癌栓。从病理情况以及影像学情况看,肿瘤已经比较晚了,出现了梗阻情况,肿瘤引流区域出现了多发淋巴结转移,并且有脉管侵犯现象。这种有脉管侵犯的病人往往容易出现远处转移,特别是肿瘤较晩的病人,治疗方面应该联合化疗,必要时加靶向药物治疗。但是由于这个病人全身情况差,营养状况和心肺功能都很差,所以没有进行联合化疗,术后一个月口服单药化疗加中药治疗,每三个月定期复查一次。

术前CT显示降结肠被肿瘤堵塞后扩张

降结肠肿瘤位置

术后病理检查

病理检查图片
术后一年半的时候,常规复查时发现病人双肺出现明确的转移病灶,但患者一般情况及营养状况比术前有所好转,随后给予联合化疗和靶向药物治疗。

肺部CT显示左右肺均有转移病灶
经联合化疗及靶向药物治疗六个周期后,病人双肺的转移病灶完全消失,随后进行维持治疗至今没有发现新的转移病灶。
6个周期化疗及靶向药物治疗后转移病灶完全消失
结直肠癌术后最常见的转移部位为肝脏,第二常见的转移部位为肺部。对于结直肠癌术后出现的肺转移瘤,应根据肺转移瘤的数目、位置、大小、原发病灶及肺外转移灶的情况综合制定治疗方案,必要时要进行多学科综合会诊讨论决定治疗方案。如果肺转移灶可切除,同时原发灶切除术后未接受过化疗,或完成化疗超过12个月,且肺转移灶切除后有复发高危因素时可先采用联合化疗。肺转移发现前12个月内接受过化疗的病人,如能做到Ro切除,可直接切除肺转移灶。对于具有潜在可切除肺转移病灶患者,先行新辅助治疗进行转化,如果转化成功,则按可切除的原则进行处理;如果转移灶经转化治疗后完全消失,可进行维持治疗;如果转化不成功,则按不可切除的肺转移癌进行处理,必要时更换化疗方案进行全身化疗,每6~8周进行评估一次。有条件的病人还可行基因检测,看看有无更合适的靶向药物和免疫治疗药物,当然还可加用中医中药治疗。所以,对结直肠癌肺转移病人仍应进行科学治疗,不能轻言放弃!